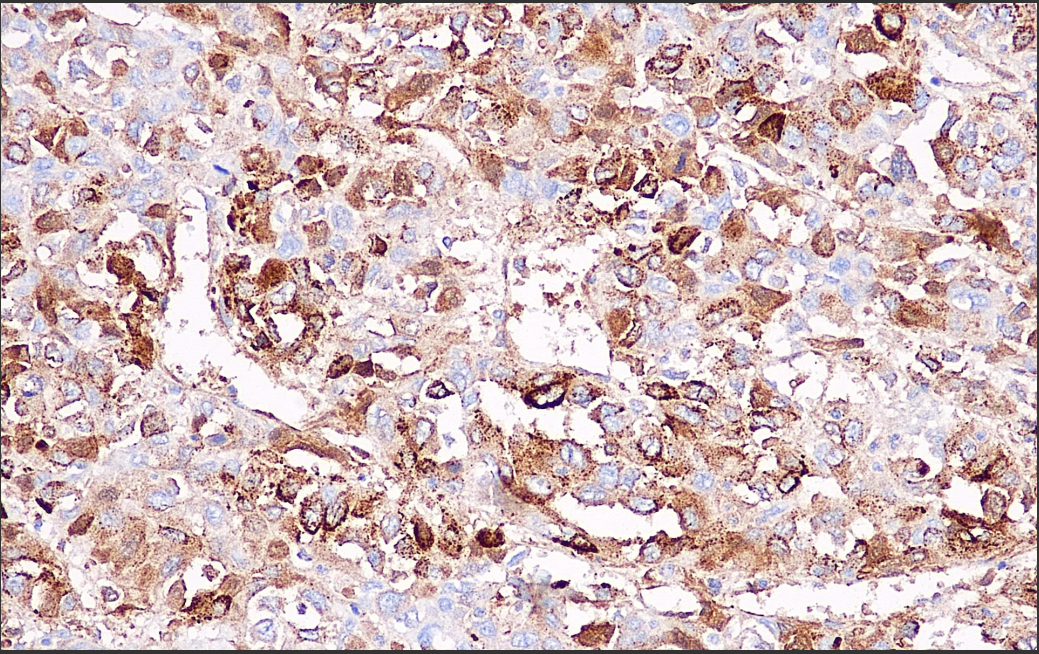

380741286440


- Home
- About Us
- Products
Conventional tissue pathology product series Liquid based cell pathology product series Special staining pathology product series Immunohistochemistry Molecular Pathology Product Series Fluorescence in situ hybridization (FISH) molecular pathology product series In situ PCR+NGS molecular pathology product series Gene mutation detection product series Digital Pathology and Instrument Equipment Product Series Innovative product series for precise pathological diagnosis Tumor Precision Diagnosis Product Series Non tumor difficult disease pathological diagnosis product series Accompanying diagnostic product series Advanced Pathological Diagnostic Technology Product Series Flow cytometry pathology product series Electron microscopy pathology and tissue chip pathology product series
- Application
- Industry
- Recruitment
- Partner
- Service
- Contact Us
- English



 0752-2228195
0752-2228195